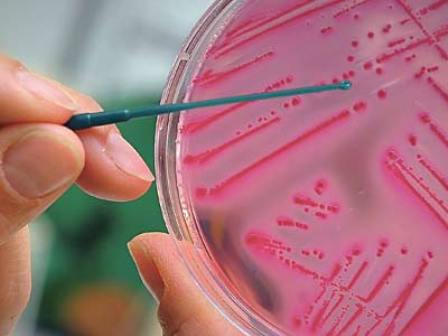

Maurice de Jong
Redacteur

Redacteur


De Voedsel en Waren Autoriteit gaat minder intensief containers uit Japan controleren op radioactieve besmetting.
Het universiteitsziekenhuis van Münster in Duitsland ontwikkelde een sneltest om de EHEC-bacterie snel te kunnen opsporen.

Het zou logisch zijn dat de komkommers besmet raakten met EHEC-bacterie via oppervlaktewater vervuild met uitwerpselen van vee of wilde dieren, stelt voedselveiligheidsexpert Martin Michels en tevens hoofdredacteur van de Nieuwsbrief Voedselveiligheid.

De Voedsel en Waren Autoriteit (nVWA) onderzocht de afgelopen dagen 168 voedselmonsters, maar trof hier geen EHEC-bacterie in aan.

Een tweede Nederlander liep besmetting op met de EHEC-bacterie en de vrees is dat de situatie zal verergeren.

Het Centraal Bureau Levensmiddelenhandel (CBL) wil dat er snel duidelijkheid komt over de bron van de EHEC-bacterie, die in Duitsland voor sterfgevallen zorgt. Samen met het Productschap Tuinbouw en het ministerie van EL&I vindt maandagmiddag 30 mei spoedoverleg plaats.

De meeste kip in supermarkten is besmet met de ESBL-bacterie. Zelfs in 85% van alle biologische kip zit de ziekteverwekker.

De Voedsel en Waren Autoriteit (nVWA) bekijkt of er mogelijk groente uit Noord-Duitsland met de EHEC-bacterie in Nederland terecht is gekomen.
De Cheersch verdwijnt en het Amstel Tapje verschijnt. Net nu Grolsch zijn thuistap van de markt haalt, introduceert concurrent Amstel een tap voor in de huiskamer. Het 'Amstel Tapje' is een innovatieve allesinéénthuistap in een eenmalige PETverpakking. Hierdoor is een tapsysteem niet nodig
Na jaren van discussie en onderzoek kwam het er afgelopen maart dan eindelijk van: het Ik Kies ewust-logo en het Gezonde Keuze Klavertje van Albert Heijn gingen samen tot één landelijk oedselkeuzelogo. Zo werd voldaan aan de wens van de overheid om te komen tot één logo en één set criteria voor toekenning hiervan.
FreshRecruitment
FreshRecruitment
FreshRecruitment
Fresh Recruitment
Bakels International Trading